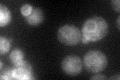
YBR036C
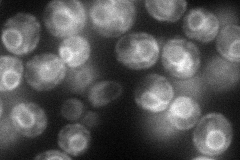
YBR036C
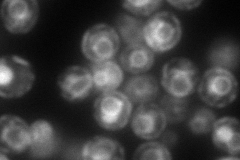
YBR036C
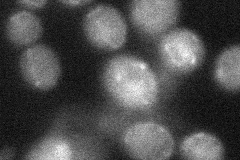
YBR036C
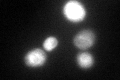
YBR036C
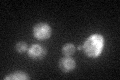
YBR036C
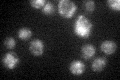
YBR036C

View description
Endoplasmic reticulum membrane protein, required for mannosylation of inositolphosphorylceramide and for growth at high calcium concentrations
Localization:
Intensity:
Fold change:
Significance:
-
C’ GFP library in SD
ER:vacuole49.62 -
N' NOP1pr-GFP in SD
ER86.6206 -
N' TEF2pr-mCherry in SD
ER,vacuole172.098 -
N' NATIVEpr-GFP in SD

ambiguous32.8049 -
N' TEF2pr-VC and Cyto-VN in SD
below threshold28.9374 -
C’ GFP library in SD+DTT
ER.vacuole73.841.48Yes -
C’ GFP library in SD+H2O2
ER.vacuole32.10.64No -
C’ GFP library in Starvation Media
ER,vacuole46.270.93No -
C’ GFP library on the background of Pup2-DaMP

ER:vacuole -
C’ GFP library on the background of CCT mutant

ER:vacuole41.87670.843749No
